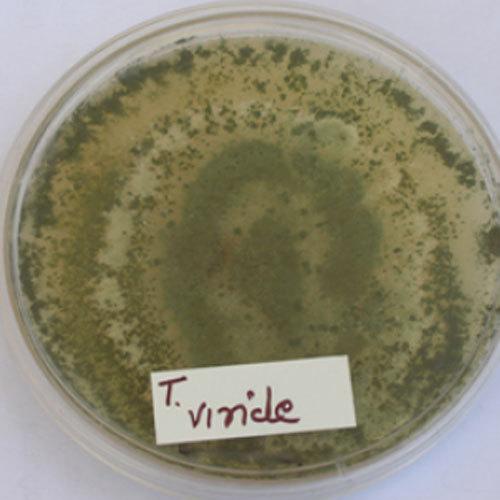
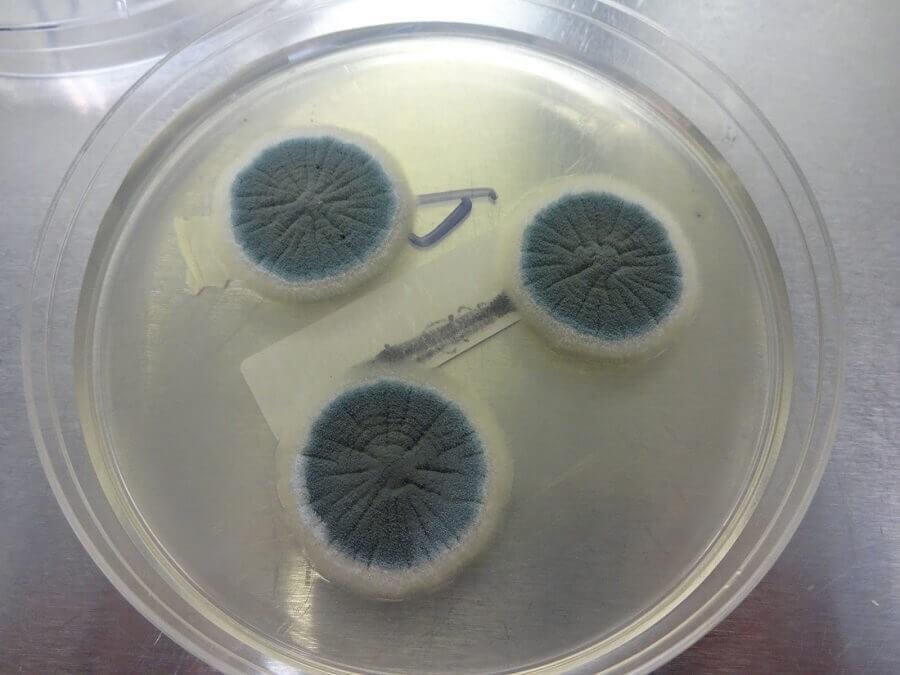
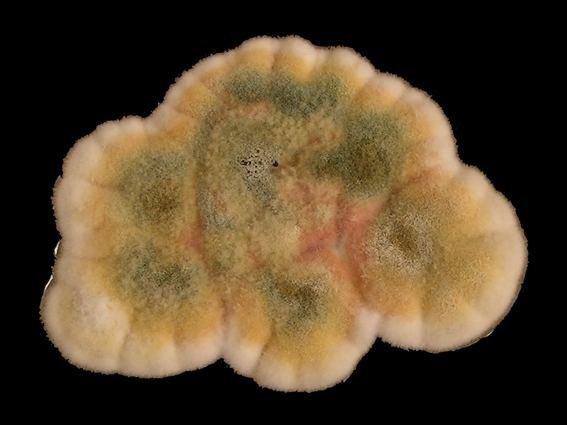

Contaminaciones


Al incursionar en el fascinante mundo de los hongos y su cultivo, el novato neófito o hasta el cultivador más experimentado se encuentra en riesgo a lo largo del camino debido a ciertos factores que pueden entorpecer o echar a perder el proceso. Ya sea por microorganismos como los mohos, bacterias y algunos factores ambientales como los mosquitos. Por lo tanto, para el cultivador en proceso o con experiencia, es importante identificar estas fuentes de contaminación para así reducir daños en el cultivo y posibles riesgos a la hora de la ingesta, en pro de aplicar buenas prácticas y evitar complicaciones en la salud. No está de más decir que en el mundo de la fungicultura hay que tener una rigurosa asepsia y limpieza, tanto en el entorno, como en los implementos, equipos y en el proceso. A pesar de haber muchos mitos en cuanto a su exagerada precaución, hay contaminaciones demasiado difíciles de tratar que, en las últimas y algunas situaciones, no le queda sino al cultivador restablecerse en un nuevo lugar o sitio. Por lo tanto, a continuación van a tener una guía detallada de cada una de estas contaminaciones.

Penicillium spp. es uno de los tipos de contaminantes más comunes en el cultivo de hongos con psilocibina. Las esporas del hongo Penicillium se encuentran normalmente esparcidas por el aire de todo el Mundo y pueden contaminar fácilmente el grano por lo que deben evitarse corrientes de aire en el laboratorio. Luego, el moho puede colonizar en el grano o en el pan donde se propaga rápidamente y puede incluso apoderarse de todo el micelio del hongo aniquilándolo. Aunque cabe destacar que una contaminación por Penicillium normalmente comienza como un moho de color blanco, lo que al principio puede dificultar la distinción del micelio del hongo ya que el micelio de Psilocybe spp. es al igual blanco. Sin embargo las colonias de Penicillium suelen tener forma circular. El Penicillium aparece a menudo en la madera, razón por la cual los cultivadores de hongos deben evitar cualquier inmobiliario de madera, si es posible no contar con muebles o piso de madera en el laboratorio de cultivo. Afortunadamente, la contaminación por Penicillium rara vez ocurre en el proceso de fructificación. La mayoría de las veces, afecta a los granos no colonizados. Penicillium tiene un olor a suciedad característico.
Una vez que el grano se ha contaminado de Penicillum es necesario desecharlo asegurando una profunda limpieza en todo el laboratorio. Así mismo asegurar de comprar grano de buena calidad y esterilizarlo a las temperaturas óptimas.
Este contaminante es posiblemente el más común y uno de los más agresivos. El moho verde causado por Trichoderma harzianum se caracteriza por formarse a través de un micelio blanco muy agresivo que crece sobre el pan y sobre el micelio, provocando una decadencia crónica del cultivo. Las masas de esporas que eventualmente se forman son de color verde esmeralda. Ésta es actualmente el contaminante más importante en la industria del cultivo de setas. Otros mohos verdes pueden definirse mejor como indicadores, ya que no parecen ser tan agresivos como T. harzianum. Pero no debemos confiarnos ya que el Trichoderma viride produce toxinas que disuelven las paredes de las células de los hongos. Trichoderma a menudo se confunde con los mohos Penicillium o Aspergillus y viceversa, ya que los tres se ven muy similares y no son fáciles de distinguir sin el uso de un microscopio.

Este contaminante es posiblemente el más común y uno de los más agresivos. El moho verde causado por Trichoderma harzianum se caracteriza por formarse a través de un micelio blanco muy agresivo que crece sobre el pan y sobre el micelio, provocando una decadencia crónica del cultivo. Las masas de esporas que eventualmente se forman son de color verde esmeralda. Ésta es actualmente el contaminante más importante en la industria del cultivo de setas. Otros mohos verdes pueden definirse mejor como indicadores, ya que no parecen ser tan agresivos como T. harzianum. Pero no debemos confiarnos ya que el Trichoderma viride produce toxinas que disuelven las paredes de las células de los hongos. Trichoderma a menudo se confunde con los mohos Penicillium o Aspergillus y viceversa, ya que los tres se ven muy similares y no son fáciles de distinguir sin el uso de un microscopio.
En cultivo casero se recomienda desechar inmediatamente cualquier cultivo que haya sido contaminado por este hongo en particular. En cultivo casero si se ha detectado a tiempo se recomienda retirar el área infectada de nuestro pan con pinzas estériles y colocar una gota de agua oxigenada. De todas maneras muchas granjas micológicas esparcen sal sobre las áreas afectadas cuando se reconoce por primera vez al moho verde. La higiene estricta es esencial. Las superficies de las estanterías, bandejas, paredes, pisos, herramientas etc. Deben desinfectarse rutinariamente. Hay muchos productos comerciales disponibles para limpiar superficies que normalmente incluyen cloro, yodo, fenol o amonio cuaternario, entre otros. Podemos comprar las sustancias por separado y mezclar en una solución al 10% del producto con 90% de agua potable. Los desinfectantes de superficies se utilizan en toda la granja, desde la limpieza del set-up y el equipo hasta el lavado de la habitación. Un abono húmedo con bajo contenido de amoníaco antes de la pasteurización, moscas, malas condiciones sanitarias, anaerobiosis y otros factores influyen en el moho verde. Estos hongos son comunes en el aserrín y en la fibra de coco.
El Aspergillus spp. es muy común en cultivos de agar y granos, también suele contaminar bulks. Puede ser encontrado en casi cualquier sustrato orgánico, aunque cabe aclarar que el Aspergillus prefiere un pH casi neutro. Las especies varían en color de amarillo aunque con mayor frecuencia, las especies de Aspergillus son verdosas y similares a Penicillium. Aspergillus niger, como su nombre lo indica, es negro; Aspergillus flavus es amarillo; Aspergillus clavatus es azul verdoso; Aspergillus fumigatus es verde grisáceo; y Aspergillus veriscolor exhibe una variedad de colores (verdoso a rosado a amarillento). Estos mohos, como muchos otros, cambian de color y apariencia según el medio en el que se encuentran. Varias especies son termofílicas (Tienen preferencia por altas temperaturas).

Es importante saber que algunas especies de Aspergillus son TOXICAS. Aspergillus flavus, una especie de color amarillo a verde amarillento, produce aflatoxinas que de todas las toxinas producidas biológicamente, son los hepatocarcinógenos más potentes encontrados hasta ahora. Aspergillus fumigatus y Aspergillus niger, otros dos mesófilos termotolerantes, también son patógenos que pueden poner en riesgo la vida humana en cantidades concentradas. La afección se llama aspergilosis o "Enfermedad pulmonar del trabajador de hongos". De cualquier forma A. flavus tiene por preferencia las harinas de semillas de maíz, maní y otras semillas con alto contenido de aceite que se han almacenado en ambientes cálidos y húmedos. Dado que A. flavus crece prácticamente en todos los tipos de grano, esta especie es motivo de grave preocupación para los productores de hongos. El manejo cuidadoso de cualquier moho, particularmente los del género Aspergillus, debería ser una responsabilidad primordial de todos los cultivadores de hongos. Se recomienda que ante la aparición de este contaminante este sea desechado de forma inmediata.
Se trata de un micelio algodonoso que crece en la superficie de nuestro pan. Cuando el hongo Hypomyces spp. entra en contacto con un hongo, el contaminante envuelve al hongo con un micelio suave, mohoso, conformado de muchas “hebras” muy finas dando la apariencia de una telaraña y causa una podredumbre suave. Interesantemente este hongo parasita hongos silvestres. ¿Cómo lo identificamos si también es blanco como el micelio de Psilocye? El Coweb es definitivamente más oscuro que el micelio de Psilocybe. Este es casi gris en comparación con el blanco. La diferencia de color a veces es difícil de percibir para alguien con poca experiencia por lo que muchas veces suele aniquilar nuestros cultivos sigilosamente ya que es de sorprendentemente rápido crecimiento, incluso llegando a colonizar por completo nuestro cultivo en cuestión de un par de días.

El micelio de Hypomyces se ve favorecido por la alta humedad. Las estrategias de control incluyen reducir la humedad y / o aumentar la circulación de aire generando más agujeros en nuestro Monotube asegurándonos siempre de que el entorno esté libre de contaminantes mediante un uso integral de las herramientas de esterilización.
Es común que este contaminante aparezca ocasionalmente en agar y en grano. La Neurospora es de rápido crecimiento, incluso tomando solo 24 horas para colonizar totalmente una placa de Petri llena de micelio. Es omnipresente en la naturaleza y se encuentra en el estiércol, en el suelo y en la materia vegetal en descomposición. Dado que este hongo crece a través de los tapones de algodón u otro tipo de filtro por donde circule el aire del tarro o el Monotube, un solo frasco contaminado, por ejemplo, aunque esté sellado, podría esparcir las esporas a los frascos de pasteurización adyacentes dentro del laboratorio. Esta condición es más probable si los filtros o los tapones de algodón están demasiado humedos; o si la humedad externa es alta. Además, las esporas de Neurospora colonizan más rápidamente a temperaturas elevadas por lo que es mas probable su aparición. El moho rosado que se observa en el cultivo de hongos con mayor frecuencia es Neurospora sitophila. ¿Cómo controlar Neurospora? Es un contaminante pernicioso que es difícil de eliminar. Todos los cultivos infectados deben retirarse del laboratorio lo antes posible y destruirse. Es absolutamente necesaria una limpieza a fondo del laboratorio. Si la contaminación persiste, elimine todas las reservas y comienza de nuevo.

Los síntomas de la aparición de este contaminante incluye hongos malformados con estípites hinchados y sombreros reducidos o deformados. El tejido indiferenciado se vuelve necrótico y puede seguir una pudrición suave y húmeda con un olor desagradable. Aparece un líquido ámbar en los hongos infectados y Los hongos se vuelven de color marrón. Increíblemente este hongo al colonizar forma una clase de burbuja que puede ser tan grande como una naranja. El hongo se propaga a través del polvo en el aire y la carcasa contaminada. También es un parásito de las setas silvestres. ¿Cómo controlarlo? Los controles incluyen saneamiento y en algunos países el uso del compuesto Sporogone, que también es muy eficaz contra Verticillium.

Este contaminante es causado por el hongo Verticillium, una especie que produce esporas pegajosas. Los síntomas producidos varían con la etapa de desarrollo del hongo en el momento de la infección. La infección 'temprana' forma un pinning que da como resultado la producción de sombreros deformados, que se vuelven de color gris o marrón y permanecen correosas. La infección en una etapa posterior provoca un engrosamiento del estípite, especialmente en la base, y también un hongo torcido con una tapa inclinada y un tallo pelado hacia atrás. Esta infección puede ocurrir en una etapa muy tardía del desarrollo del cultivo, dando lugar a manchas superficiales circulares, inicialmente de color marrón pálido que se vuelven grises con la edad hasta fructificar los órganos sexuales; las setas. ¿Cómo evitarlo? Evita poner en el suelo tus incubadoras o fructificadoras en el suelo. Tome medidas para evitar la acumulación de polvo en las proximidades de las fructificadoras o incubadoras de hongos o dentro del armario del cultivo. Es fundamental controlar las moscas que puedan colocarse sobre la zona de cultivo y se deben hacer todos los esfuerzos posibles para evitar su entrada a los monotubes. A medida que aparezcan alguno de estos hongos, deben retirarse del pan con un paño o esponja empapados en desinfectante (Solución con alcohol, peróxido o agua oxigenada) intentando solo quitar la zona afectada y luego colocarla en un recipiente que contenga desinfectante con un 15%-20% cloro y agua. Después agrega sal de mesa en la zona afectada.

Un hongo de crecimiento muy rápido por lo que es casi imposible de eliminar. Una vez que esporula, forma muchas hifas como alfileres con una esfera en la parte superior, tal y como son los pines. Crece en carbohidratos fácilmente disponibles. Junto con Aspergillus y Penicillium, las especies de este género son los principales contaminantes de grano. También es muy común en paja. ¿Cómo controlarlo? Ya que los fungicidas incluso especializados para controlar Rhizopus pueden ser exponencialmente dañinos para el hongo Psilocybe, se recomienda desechar todo el material infectado y limpiar de forma enfatica todo el laboratorio. Evitar frutas como duraznos en la zona.

La aparición de estos cuerpos fructíferos como algunos otros contaminantes son evidencia de amoníaco libre en el monotube o zona de cultivo. El amoníaco parece ser una fuente de nitrógeno. Sus delicados y aguados casquillos grises se auto-digieren rápidamente. De sus sombreros escurren “tapones de tinta” los cuales son indicadores de un exceso de suplementación de nitrógeno o un sustrato mal administrado a la hora del proceso de fructificación. Si hay demasiado amoníaco residual, es posible que la microflora termofílica de la fase de fructificación no pueda convertir todo el amoníaco en proteína microbiana. Además, las áreas en el abono que no permanecieron dentro del rango de 46 a 60 C° de 72 a 96 horas después de la pasteurización pueden contener amoníaco residual. Este hongo es fuertemente celulolítico. ¿Cómo controlarlo? Acaba siendo un indicador mas que un contaminante altamente peligroso, por lo que se recomienda retirar la zona afectada colocando agua oxigenada en la zona o en el peor de los casos si ha colonizado lo suficiente, desechar el pan y asegurarnos de generar una pasteruización con las temperaturas adecuadas para evitar el amoniaco residual que atrae a esta especie de contaminante.

Este moho suele aparecer junto al hongo Coprinus. Produce un crecimiento de color gris claro en la superficie del sustrato, y luego se vuelve marrón a medida que maduran las esporas. Forma estructuras erectas con racimos esféricos de grandes esporas en su extremo superior. Este moho indica que el amoníaco y las aminas no se eliminaron por completo durante la fase de pasteurización.

Los adultos son moscas pequeñas (1/8 de pulgada de largo), frágiles de gris a negras con patas largas y delgadas y antenas filiformes. Sus alas son claras o de color ahumado sin patrón y con pocas venas distintas. Las larvas son de color claro a blanco cremoso y pueden crecer hasta aproximadamente 1/4 de pulgada de largo. Tienen cápsulas de cabeza negra brillante.


Se sienten atraídos por el cultivo de hongos y sus larvas se alimentan directamente del micelio, pululan sobre el hongo y hacen un túnel hacia el hongo en desarrollo o desarrollado. Los tejidos que han sido dañados físicamente por las moscas a menudo son colonizados por bacterias que causan podredumbres en el micelio, lo que acentúa el problema. ¿Cómo controlarlo? Los controles incluyen el saneamiento estricto e higiene general del laboratorio. Por ejemplo, el cuarto de cultivo debe ser hermético. Debe haber un buen filtrado, incluso una pequeña grieta servirá como entrada para las moscas. La mayoría de las granjas usan cinta adhesiva de tipo micropore o algún otro método que permite monitorear la circulación del aire. Un biocontrol que utiliza nematodos ofrece un control eficaz cuando las poblaciones de moscas son bajas. Además del daño que causan las larvas de mosca al comer micelio de hongos, los adultos también son portadores de otras esporas como Verticillium, Mycogone o Cobweb.
Muchos ácaros se encuentran comúnmente en la paja y el estiércol, la mayoría de las especies son beneficiosas para el cultivo de hongos ya que se alimentan de residuos tanto del hongo Psilocybe, como de otros contaminantes, como de otros acaros, aunque algunas especies si pueden causar daños a nuestro cultivo. Los ácaros, como las larvas de mosca, pueden alimentarse del micelio del hongo y de las setas, donde pueden causar decoloración de la superficie. También pueden vivir de otros hongos que se encuentren en el casing. Un ejemplo es el pimiento rojo o el ácaro pigmeo (Pymephorus spp.). Estos ácaros se asocian comúnmente con los mohos Penicillium y Trichoderma, de los que se alimentan. Los ácaros pigmeos no se alimentan de Agaricus. Estos ácaros tienen la capacidad de cambiar a una etapa intermedia llamada hipopo, en la que desarrollan cuerpos aplanados y una placa de succión con la que se adhieren a objetos en movimiento, como moscas. En esta etapa, los ácaros pululan sobre los hongos.

Estos ácaros son de color marrón pálido y son tan diminutos que solo son visibles con la ayuda de un microscopio. Causan daño al alimentarse enteramente de hifas de hongos y el cultivador sabrá si tiene estos ácaros presentes, ya que la base del tallo del hongo mostrará una decoloración marrón rojiza. Cuando ocurren infestaciones severas, toda la base del hongo puede desprenderse de la superficie de crecimiento. ¿Cómo controlarlo? Poco se puede hacer cuando los ácaros están presentes en el monotube, por lo tanto, se debe realizar una mezcla de grano y sustrato eficiente y un calentamiento optimo de estos mismos para asegurar que mueran durante el proceso de pasteurización. Asegurate de eliminar completamente los restos de otros cultivos ya que también pueden atraerlos.

Las estructuras fructíferas de este moho parece mucosa de color verde oliva de unos 3 cm máximos de diámetro los cuales se desarrollan en el sustrato en el proceso de fructificación o en el grano durante la incubación. Aunque sus esporas son tolerantes al calor (Pueden sobrevivir a 140 F durante 6 horas), el moho aparece solo en el compost manejado incorrectamente durante la fase de fructificación, especialmente cuando la ventilación de Ios monotubes es inadecuada.
La falta de oxígeno o cuando la temperatura donde crece el micelio es superior a 61 F favorece la formación de patógenos tóxicos producidos en condiciones anaeróbicas de los cuales se alimenta el hongo Cheatomium. Una manera de evitarlo es asegurándonos de contar con un buen sistema de ventilación y un buen manejo de temperaturas. Si el hongo ya ha colonizado se recomienda desechar todos los panes y satinizar enfáticamente el laboratorio.